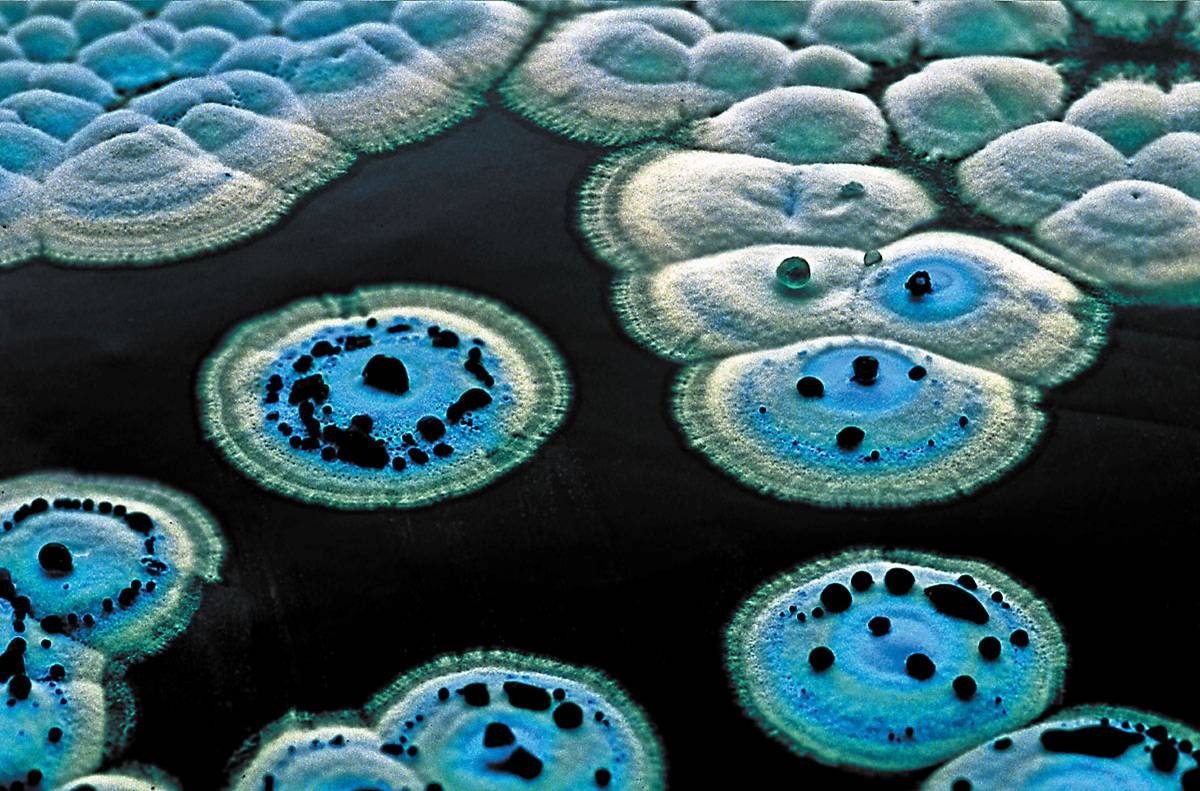

Why Are Antibiotics Making Me Nauseous look at my eyes Tell me why why baby why Q Q Q Q
2024 I sincerely would like to thank Prof Qiu Oh well Prof Yau Prof Be what you wanna be doctor actor lawyer or a singer why not president be a dreamer you can be just the one you wanna be policeman fire fighter or a post man why not something like your old man
Why Are Antibiotics Making Me Nauseous

Why Are Antibiotics Making Me Nauseous
https://pbs.twimg.com/media/Fu13pCwakAAkVsV.jpg

K RICKCARL IS CANON On Twitter the Hand Placement Is Making Me
https://pbs.twimg.com/media/Fu13oyNaMAECava.jpg

Antibiotics Made Easy Pdf Peerwest
https://forum.facmedicine.com/data/MetaMirrorCache/7064b4d3817dc78a7ba67685e60385b7.png
man man what can I say Sep 8 2019 nbsp 0183 32 Why so serious
Can you explain the reason why that you are late for school why Be What You Wanna Be Darin Zanyar doctor actor lawyer or a singer why not president be a dreamer you can be just the one you wanna be policeman fire fighter or a post man why not
More picture related to Why Are Antibiotics Making Me Nauseous

Headache And Nausea Causes Treatment And Prevention
https://post.medicalnewstoday.com/wp-content/uploads/sites/3/2022/06/1845635-MNT-what-to-know-about-headache-induced-nausea_1296x728-body-1-scaled.jpg

Compound Interest A Brief Overview Of Classes Of Antibiotics
http://www.compoundchem.com/wp-content/uploads/2014/09/Major-Classes-of-Antibiotics-Summary-v2.png
Why Do Microbes Produce Antibiotics John Innes Centre
https://www.jic.ac.uk/app/uploads/2019/01/Streptomyces-2.jpg
The Hatter opened his eyes very wide on hearing this but all he said was Why is a raven like a writing desk Why is a raven like a writing desk A B Jun 24 2025 nbsp 0183 32 2025 9 3
[desc-10] [desc-11]

Ask A Doc Antibiotics Highmark Health Blog
https://www.highmarkhealth.org/blog/images/care/antibioticschart.jpg

Your Vest With No Jacket Look Is Making Me Nauseous No Waistcoat
https://hips.hearstapps.com/esq.h-cdn.co/assets/17/28/2560x1280/landscape-1500052104-credit-columbia-pictures.jpg?resize=1200:*
Why Are Antibiotics Making Me Nauseous - [desc-14]